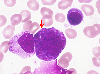

|    |

全登録症例数:225
全登録画像数:1755
全登録画像数:1755
本例は、末梢血および骨髄の芽球の比率ではMDSのRAEB-Ⅱを満たすものであったが、異型の好酸球の増加が診断を裏付ける格好となった。染色体はinv(16)(13.1q22)の核型異常を認め、FISH法にてCBFB遺伝子の異常を認...
(続きを読む) 本例は、末梢血および骨髄の芽球の比率ではMDSのRAEB-Ⅱを満たすものであったが、異型の好酸球の増加が診断を裏付ける格好となった。染色体はinv(16)(13.1q22)の核型異常を認め、FISH法にてCBFB遺伝子の異常を認めたことからinv(16)(13.1q22)/CBFB-MYH11を伴うMDS(RAEB-Ⅱ)と診断された。
(たたむ)
(続きを読む) 本例は、末梢血および骨髄の芽球の比率ではMDSのRAEB-Ⅱを満たすものであったが、異型の好酸球の増加が診断を裏付ける格好となった。染色体はinv(16)(13.1q22)の核型異常を認め、FISH法にてCBFB遺伝子の異常を認めたことからinv(16)(13.1q22)/CBFB-MYH11を伴うMDS(RAEB-Ⅱ)と診断された。
(たたむ)
■症例詳細データ
| 性別 | 男 |
|---|---|
| 年齢 | 70-74 |
| 取得年代 | 2010-2014 |
| 主訴 | 全身倦怠感 |
| 既往歴 | 膀胱癌(1年前) |
| 現病歴 | 膀胱癌の治療後に汎血球減少を来したため当院の血液内科に紹介された。 |
| 検査所見 | WBC2,500/μl(Blast 3%,Seg42%,Ly44%,Mo10%,Eo1%)、RBC210万/μl、Hb6.8g/dl、Ht20.6%、MCV98.0fl、MCH32.3pg、MCHC33.0%、PLT9.4万/μl 、BM-NCC 6.2万/μl、MgK31/μl、 TP6.2g/dl、Alb 3.6g/dl、AST41IU/l、ALT10IU/l、LDH140IU/l、γ-GTP60IU/l、BUN34mg/dl、Cre9.1mg/dl、CRP1.8mg/dl |
| 末梢血所見 | 汎血球減少で白血球減少(2,500/μl)のもと芽球が3%みられた。好中球には二核で細い核糸をもつものや糸状核の突起を有する異形成が散見された。単球は分葉核ものがみられた。 |
| 骨髄所見 | 低形成の骨髄はM/E比は2.3で芽球は12%みられた。芽球のなかには大型で、核形不整や豊富な細胞質を有するものがみられ異型性を思わせた。背景には好酸球が10%と増加し、そのなかで大型で好塩基性の粗大顆粒を有するものが5%みられ、形態学的には異型性の好酸球として捉えた。他に顕著な異形成は認めなかった。 Blast12%,Promy4,My4,Met9,St11,Seg10,Ly13,Mo4,Eo10,ProEbl.1,PolyEbl.24,OrthEbl.1 |
| 細胞化学所見 | 芽球はPO染色に陽性でブチレートEST染色は陰性であった。異型の好酸球はPO染色に強陽性で、クロロアセテートEST染色に陽性、PAS染色に陽性を呈した。 |
| 形態診断 | 芽球は末梢血に3%出現し、骨髄に12%みられたことよりMDSのRAEB-Ⅱ型を考えた。しかも、異型の好酸球がみられたことから染色体におけるinv(16)の核型異常を疑った。 |
| 免疫学的所見 | CD13・CD33・CD34・HLA-DR(+) |
| 分子生物学的所見 | 46,XY、inv(16)(13.1q22) [16] 46,XY [4] CBFB (FISH法):100細胞中スプリットシグナルは35.0% |
| リンパ節所見 | N.D |
| 臨床診断 | 末梢血および骨髄の芽球の比率はMDSのRAEB-Ⅱを満たすものであったが、異型の好酸球の増加が診断を裏付ける格好となった。染色体はinv(16)(13.1q22)の核型異常を認め、FISH法にてCBFB遺伝子の異常を認めたことからinv(16)(13.1q22)/CBFB-MYH11を伴うMDS(RAEB-Ⅱ)と診断された。 |